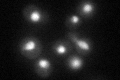
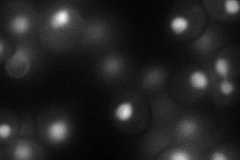
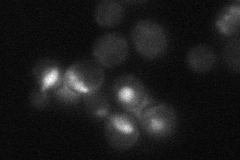
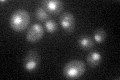

View description
Cyclin for the Sgv1p (Bur1p) protein kinase; Sgv1p and Bur2p comprise a CDK-cyclin complex involved in transcriptional regulation through its phosphorylation of the carboxy-terminal domain of the largest subunit of RNA polymerase II
Localization:
Intensity:
Fold change:
Significance:
-
C’ GFP library in SD
nucleus41.1 -
N' NOP1pr-GFP in SD
nucleus74.0254 -
N' TEF2pr-mCherry in SD

vacuoleN/A -
N' NATIVEpr-GFP in SD
nucleus20.9577 -
N' TEF2pr-VC and Cyto-VN in SD

#N/A0 -
C’ GFP library in SD+DTT

nucleus32.490.79No -
C’ GFP library in SD+H2O2

nucleus40.330.98No -
C’ GFP library in Starvation Media
nucleus48.961.19No -
C’ GFP library on the background of Pup2-DaMP

nucleus -
C’ GFP library on the background of CCT mutant

nucleus35.18010.855774No
